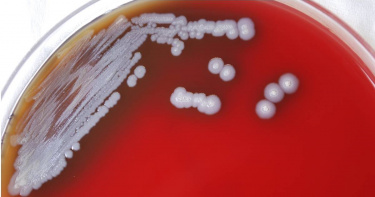
alt

類鼻疽病
」 類鼻疽 颱風 疾管署 山陀兒 高雄
丹娜絲颱風後積水嚴重「鉤端螺旋增5例」 疾管署:再添類鼻疽死亡個案
丹娜絲颱風不僅帶來強風豪雨,風災後因為積水嚴重,疾管署今天公布,國內新增2例類鼻疽本土病例死亡個案,其中1例死亡、5例鉤端螺旋體病。疾管署發言人曾淑慧提醒,颱風後一個月內,都是傳染病高風險傳染時期,民眾災後復原整理家園時重建時,一定要佩戴口罩、穿雨鞋、戴手套等,避免接觸與吸入感染。疾管署公布,上周(8/13-8/18)新增1例本土類鼻疽病例,為居住中部80多歲;另新增1例死亡個案,為居住在南部市70多歲男性。2例均有慢性病史、無汙水汙泥相關接觸史。今年累計41例本土病例,其中4例死亡,病例數歷年同期第三高。疾管署防疫醫師林詠青說明,死亡的本土類鼻疽個案是一名南部70多歲男性,有高血壓、慢性腎病,六月中旬咳嗽發燒腹痛,兩度就醫症狀沒有改善,發病第六天胸悶、腹痛到急診就醫,X光顯示兩側肺炎,就醫隔天因為呼吸困難,轉入加護病房治療,醫院血液培養出類鼻疽病菌,住院期間因為併發腎衰竭、敗血性休克,七月上旬死亡 發病後三週死亡 死因爲菌血症,併發肺炎和呼吸衰竭。疾管署說明,今年國內累計41例類鼻疽本土病例,含4例死亡,為歷年同期第3高,分布縣市以高雄市30例最多,其次為台中市7例、台南市3例、屏東縣1例,其中19例於丹娜絲颱風後發病,分布高雄市14例、台中市3例及台南市2例。疾管署表示,風災後,類鼻疽和鉤端螺旋體個案持續增加。(圖/中國時報記者鄭郁蓁攝)鉤端螺旋體病部分,上周(8/13-8/18)新增5例本土病例,其中2例有汙水汙泥相關接觸史;今年累計28例本土病例,低於近5年同期,其中14例於丹娜絲颱風後發病,分布在台中市5例、高雄市2例、台北市、基隆市、彰化縣、南投縣、嘉義縣、台南市及花蓮縣各1例疾管署提醒,類鼻疽之病原菌存在於受污染的土壤、水池及積水環境中,由於強風暴雨易使土壤及泥水中的病原菌暴露於地面並更易傳播,除了接觸傳播外尚可能經由食入受污染的水或吸入性感染。而鉤端螺旋體廣泛存在於齧齒類動物(如老鼠)、野生動物、寵物(狗,貓較少見)和牲畜(牛、豬、馬)等,受感染的動物可能無症狀,但其尿液大量排菌,污染水及土壤,透過皮膚或黏膜進入人體,易發生於經常接觸可能受感染動物排泄物污染之水源或屠體組織之工作者(如農民、畜牧業者等)。疾管署強調,民眾進行滅鼠工作、風災後清理家戶內外環境或因工作接觸可能受感染動物排泄物污染之水源或屠體組織,應佩戴口罩、手套及穿著長筒雨鞋,脫下裝備時記得清洗雙手;此外,如有不明原因發燒等症狀應儘速就醫,並告知醫師是否有汙水汙泥與動物接觸史及職業暴露史,以及早診斷與治療。

新增3例類鼻疽!死亡數歷年同期新高 康芮颱風來襲再拉警報
疾管署今(29)日公布國內上週新增3例山陀兒颱風後本土類鼻疽病例(其中1例死亡),均位於高雄市,年齡介於 40餘歲至70餘歲,3例均具糖尿病或慢性腎病等慢性病史,發病日介於10月11至22日,其中2例無汙水淤泥接觸史,因發燒、呼吸喘等症狀就醫,均住院以抗生素治療中。死亡個案為60多歲男性,接觸史不明,10月22日因呼吸喘就醫,當日因敗血性休克、嚴重肺炎、呼吸衰竭不幸死亡。疾管署呼籲,糖尿病、肺病、肝病、腎病、癌症或免疫功能受損者等高風險族群,感染後重症機率較高,如有發燒、胸痛、咳嗽等症狀應儘速就醫,即早診斷與治療。疾管署表示,今年國內已累計101例本土類鼻疽確定病例,其中20例死亡,為歷年同期最高,本土病例以65歲以上(59例)和50-64歲(31例)為主要年齡層,分布縣市以高雄市(77例)為多,其次為臺南市(10例)、屏東縣(4例)和臺中市(4例),其中69例於凱米颱風後1個月內發病,6例於山陀兒颱風後發病。疾管署說明,類鼻疽是由類鼻疽桿菌引起,潛伏期平均為9天,短則數小時,亦可長達21天,該菌存在於土壤、水池及積水環境中,主要由皮膚傷口接觸受病原菌污染的土壤或汙水傳染,而颱風後因強風暴雨易使土壤和泥水中的類鼻疽桿菌暴露於地面並更易傳播,且常為吸入性感染,於颱風後一個月內確診個案增加。疾管署指出,依中央氣象署發布資料,預測近期康芮颱風將於10月31日至11月1日通過臺灣或鄰近海域,且不排除中心登陸臺灣的可能,受外圍環流影響可能帶來大量降雨,疾管署呼籲高風險民眾颱風天應儘量待在室內並避免開窗及建議於室內外皆佩戴口罩,避免吸入空氣中帶有病菌的塵土或水滴,並應做好個人防護措施,避免皮膚、傷口直接接觸受汙染塵土、土壤及汙水,降低感染機會。疾管署提醒,感染類鼻疽症狀表現差異極大,可能為無症狀,而常見病徵包括發燒、頭痛、局部腫痛、潰瘍、胸痛、咳嗽、咳血及淋巴結腫大,可導致皮膚膿腫、肺炎、腦炎、敗血症,需儘速以適當抗生素治療,請民眾務必留意自身健康狀況,如出現疑似症狀時,尤其高風險族群,應儘速就醫並告知汙水、汙泥相關暴露史,以及早診斷獲得妥善治療;醫師診療遇有疑似個案,應儘速評估給予抗生素治療並於24小時內通報及採檢送驗,以利衛生單位採取防治措施。

山陀兒襲台後首例死亡個案!高雄男染類鼻疽 發病住院1週亡
疾病管制署今(22)日公布國內上週新增2例山陀兒颱風後本土類鼻疽病例(其中1例死亡),均位於高雄市,其中1例70多歲男性有慢性病及汙水/淤泥接觸史,目前仍醫院住院治療中;另一例80多歲男性因有多重慢性病史,常因呼吸困難、肺炎頻繁住院,10月7日再次出現發燒、呼吸喘,就醫住院並採檢,10月13日因肺炎及自身慢性疾病不幸死亡。疾管署表示,今年國內已累計98例本土類鼻疽確定病例(18例死亡),為2001年以來同期最高,98例本土病例以65歲以上(57例)和50-64歲(31例)為主要年齡層,分布縣市以高雄市74例為多,其次為臺南市10例)屏東縣4例和臺中市4例,其中69例於凱米颱風後1個月內發病,3例於山陀兒颱風後發病。疾管署指出,颱風過後為類鼻疽疫情高峰,1個月內仍有機會出現個案,且近期持續有颱風生成,外圍環流可能帶來大量降雨,民眾颱風天應儘量待在室內並避免開窗及建議於室內外皆佩戴口罩,避免吸入空氣中帶有病菌的塵土或水滴,並應做好其他個人防護措施,避免皮膚、傷口直接接觸受汙染塵土、土壤及汙水,降低感染機會。疾管署說明,類鼻疽是由類鼻疽桿菌引起,潛伏期平均為9天,短則數小時,亦可長達21天,該菌存在於土壤、水池及積水環境中,主要由皮膚傷口接觸受病原菌污染的土壤或汙水傳染,而颱風後因強風暴雨易使土壤和泥水中的類鼻疽桿菌暴露於地面並更易傳播,且常為吸入性感染,於颱風後一個月內確診個案增加。疾管署提醒,感染類鼻疽症狀表現差異極大,可能為無症狀,而常見病徵包括發燒、頭痛、局部腫痛、潰瘍、胸痛、咳嗽、咳血及淋巴結腫大,可導致皮膚膿腫、肺炎、腦炎、敗血症,需儘速以適當抗生素治療,請民眾務必留意自身健康狀況,如出現疑似症狀時,尤其高風險族群,應儘速就醫並告知汙水、汙泥相關暴露史,以及早診斷獲得妥善治療;醫師診療遇有疑似個案,應儘速評估給予抗生素治療並於24小時內通報及採檢送驗,以利衛生單位採取防治措施。

山陀兒襲台後首例類鼻疽!高雄男接觸汙水 呼吸困難、四肢無力住院
疾病管制署(下稱疾管署)今(15日)公布國內上週新增1例山陀兒颱風後本土類鼻疽病例,為高雄市60多歲男性,具慢性病史及汙水、汙泥暴露史,因發燒、呼吸困難、四肢無力等症狀就醫,目前住院治療中。疾管署呼籲,糖尿病、肺病、肝病、腎病、癌症或免疫功能受損者等高風險族群,重症機率較高,如有發燒、胸痛、咳嗽等症狀請儘速就醫,即早診斷與治療。疾管署表示,今年國內已累計96例本土類鼻疽確定病例(17例死亡),為2001年以來同期最高,96例本土病例以65歲以上(55例)和50-64歲(31例)為主要年齡層,分布縣市以高雄市(72例)、臺南市(10例)、臺中市(4例)和屏東縣(4例)為多,其中69例於凱米颱風後1個月內發病。疾管署說明,類鼻疽是由類鼻疽桿菌引起,潛伏期平均為9天,短則數小時,亦可長達21天,該菌存在於土壤、水池及積水環境中,主要由皮膚傷口接觸受病原菌污染的土壤或汙水傳染,而颱風後因強風暴雨易使土壤和泥水中的類鼻疽桿菌暴露於地面並更易傳播,且常為吸入性感染,於颱風後一個月內確診個案增加。疾管署指出,感染類鼻疽症狀表現差異極大,可能為無症狀,而常見病徵包括發燒、頭痛、局部腫痛、潰瘍、胸痛、咳嗽、咳血及淋巴結腫大,可導致皮膚膿腫、肺炎、腦炎、敗血症,需儘速以適當抗生素治療,提醒民眾須留意自身健康狀況,如有疑似症狀應儘速就醫治療,同時籲請醫師提高警覺,注意類鼻疽疑似個案之通報與診治。疾管署強調,颱風過後為類鼻疽疫情高峰,民眾應做好個人防護措施,避免皮膚、傷口直接接觸或吸入受汙染塵土、土壤及汙水,降低感染機會。如出現疑似症狀時,尤其高風險族群,應儘速就醫並告知汙水、汙泥相關暴露史,以及早診斷獲得妥善治療;醫師診療遇有疑似個案,應儘速評估給予抗生素治療並於24小時內通報及採檢送驗,以利衛生單位採取防治措施。

山陀兒帶來豪雨…恐再掀起「類鼻疽」疫情 7月凱米颱風後已釀13死
颱風「山陀兒」目前已減弱為熱帶性低氣壓,但在侵襲台灣期間,仍讓多地區出現積水、淹水的情況。對此,疾管署發言人羅一鈞先前就提醒,這次「山陀兒」颱風因為滯留期長,加上豪雨影響,很可能再度引起類鼻疽疫情。羅一鈞表示,今年7月下旬「凱米颱風」襲台後,當時累計了80例本土類鼻疽病例,其中13例死亡,超越2005年海棠颱風42例的最高紀錄;值得注意的是,類鼻疽潛伏期通常為2至4周,而凱米颱風過後的80例個案中,便有69例均是在颱風後1個月內發病。疾管署指出,颱風導致多地出現積水或淹水情況,民眾易因接觸污水、污泥或環境積水孳生病媒蚊,而造成感染鉤端螺旋體病、類鼻疽、登革熱及腸道傳染病等風險,籲請民眾於颱風期間及颱風過後,如需清理家園或外出時務必落實防疫措施,包括穿著雨鞋、防水手套和口罩,避免刺傷或割傷,以保障自身及家人健康安全。疾管署進一步說明,引起類鼻疽的類鼻疽桿菌存在於土壤、水池及積水環境中,主要由皮膚傷口接觸受病原菌污染的土壤或汙水傳染,而颱風後因強風暴雨易使土壤和泥水中的類鼻疽桿菌暴露於地面並更易傳播,常為吸入性感染且慢性病患感染後重症機率較高,因此颱風天應儘量待在室內,並避免開窗,建議於室內外皆佩戴口罩,避免吸入空氣中帶有病菌的塵土或水滴。颱風導致多地區積水、淹水,民眾應慎防類鼻疽。(圖/翻攝自臉書/疾病管制署 - 1922防疫達人)疾管署提醒,類鼻疽常見病徵包括發燒、頭痛、局部腫痛、潰瘍、胸痛、咳嗽、咳血及淋巴結腫大,可導致皮膚膿腫、肺炎、腦炎、敗血症,需儘速以適當抗生素治療,請留意自身健康狀況,有疑似症狀儘速就醫治療,同時籲請醫師提高警覺,如遇有疑似個案,應詢問接觸史、受災/受傷情形、汙水暴露史等,並加強疑似個案之通報與診治。另外,國際上報告類鼻疽死亡率達40到75%,國內統計近5年類鼻疽致死率則為4.5%。其中,抵抗力較差的民眾,包含糖尿病、外傷者,應避免暴露於受污染的泥土或水中,皮膚有傷口者若接觸到受污染的水或土壤,應儘快以水沖洗並就醫。

本土再添6例!凱米颱風過後「類鼻疽暴增53例」疫情重災區曝
類鼻疽疫情持續升溫!衛福部疾病管制署今(27日)公布,國內上周新增6例確診本土病例,截至目前已累計60例個案、7例死亡,其中感染類鼻疽最嚴重縣市為高雄市41人。疾管署今天表示,我國上周新增6例本土類鼻疽病例,今年已累計60例確診個案,創下自2006年以來同期新高紀錄,其中53例為凱米颱風過後的確診個案,病例分布縣市為,高雄市41例、台南市6例、台中市3例、屏東縣2例、嘉義縣1例。疾管署指出,上周新增的6例個案均居住在高雄市,年齡介於50多歲至70多歲之間,且都有慢性疾病病史,其中1例有汙水、土壤等相關環境暴露史,目前6人皆收治於一般病房治療中。對此,疾管署說明,類鼻疽桿菌存在於土壤、水池及積水環境中,主要由皮膚傷口接觸受病原菌污染的土壤或汙水傳染,而颱風後因強風暴雨易使土壤和泥水中的類鼻疽桿菌暴露於地面並更易傳播,且常為吸入性感染,造成颱風後一個月內確診個案增加,提醒民眾感染類鼻疽的常見病徵包括發燒、頭痛、局部腫痛、潰瘍、胸痛、咳嗽、咳血及淋巴結腫大,嚴重甚至恐導致皮膚膿腫、肺炎、腦炎、敗血症,應儘速就醫治療,並告知醫師有汙水、汙泥相關暴露史。

颱風後類鼻疽迎高峰再增30例「高雄最多」 已釀3死!
颱風過後為類鼻疽疫情高峰,疾病管制署表示,2024年國內已累計37例本土類鼻疽確定病例,為2006年以來同期最高,其中30例為颱風後確診個案,居住地分布為高雄市23例、台南市4例、台中市2例、嘉義縣1例,且其中包含3例死亡個案。疾管署13日公布國內上周新增19例本土類鼻疽病例,其中包含3例死亡個案,分別為高雄市15例、台南市及台中市各2例,年齡介於20多歲至90多歲,發病日介於7月24日至8月7日,其中17例具有慢性病史,7例有汙水、土壤等相關環境暴露史。而死亡個案為50多歲女性、80多歲女性及60多歲男性,均具慢性病史,因類鼻疽併發肺炎或敗血性休克死亡。其餘新確診個案14例仍住院中、其中2例於加護病房治療。疾管署呼籲糖尿病、肺病、肝病、腎病、癌症或免疫功能受損者等高風險族群,重症機率較高,如有發燒、胸痛、咳嗽等症狀請儘速就醫,即早診斷與治療。疾管署表示,依據監測資料顯示,2024年國內已累計37例本土類鼻疽確定病例,為2006年以來同期最高,其中30例為凱米颱風後確診個案,居住地分布為高雄市23例、台南市4例、台中市2例、嘉義縣1例。疾管署說明,類鼻疽是由類鼻疽桿菌引起,該菌存在於土壤、水池及積水環境中,主要由皮膚傷口接觸受病原菌污染的土壤或汙水傳染,而颱風後因強風暴雨易使土壤和泥水中的類鼻疽桿菌暴露於地面並更易傳播,且常為吸入性感染,造成颱風後一個月內確診個案增加。而類鼻疽潛伏期通常為2至4周,短則數小時,亦可長達21天,因此近期仍持續會有個案出現。此外,類鼻疽症狀表現差異極大,可能為無症狀,常見的病徵包括發燒、頭痛、局部腫痛、潰瘍、胸痛、咳嗽、咳血及淋巴結腫大,可導致皮膚膿腫、肺炎、腦炎、敗血症,需儘速以適當抗生素治療,提醒民眾須留意自身健康狀況,有疑似症狀儘速就醫治療,同時籲請醫師提高警覺,注意類鼻疽疑似個案之通報與診治。疾管署強調,颱風過後為類鼻疽疫情高峰,民眾應做好個人防護措施,避免皮膚、傷口直接接觸或吸入受汙染塵土、土壤及汙水,降低感染機會。如出現疑似症狀時,尤其高風險族群,應儘速就醫並告知汙水、汙泥相關暴露史,以及早診斷獲得妥善治療;醫師診療遇有疑似個案,應儘速評估給予抗生素治療並於72小時內通報及採檢送驗,以利衛生單位採取防治措施。

颱風效應!單周爆11例本土類鼻疽 5年同期最多「確診高峰才要來」
疾管署今(6)日表示,凱米颱風襲臺帶來強風豪雨,颱風過後國內已確診11例本土類鼻疽病例,均發生於南部縣市,分別為高雄市8例、臺南市2例及嘉義縣1例,年齡介於30多歲至80多歲,其中10位有慢性病史,另1例有酗酒史。目前個案皆住院中,其中3例仍在加護病房治療。疾管署副署長羅一鈞表示,類鼻疽最常於颱風後2到4周發病,預估至8月下旬均為確診高峰,今再度發醫界通函提醒醫師注意類鼻疽診治。依據疾管署監測資料顯示,今年國內已累計18例本土類鼻疽確定病例,為五年(2019年)以來同期最高,個案發病年齡以65歲以上年齡層為主,居住地分布為高雄市13例、台南市2例、桃園市、彰化縣及嘉義縣各1例。疾管署說明,類鼻疽是由類鼻疽桿菌引起,該菌存在於土壤、水池及積水環境中,主要由皮膚傷口接觸受病原菌污染的土壤或汙水傳染,但也可經由吸入受污染的塵土、土壤或水滴感染;而颱風後疫情常為吸入性感染,於颱風後一個月內確診個案增加。疾管署進一步指出,類鼻疽症狀表現差異極大,可能為無症狀,常見的病徵包括發燒、頭痛、局部腫痛、潰瘍、胸痛、咳嗽、咳血及淋巴結腫大,可導致皮膚膿腫、肺炎、腦炎、敗血症,需儘速以適當抗生素治療。國際上報告類鼻疽死亡率可達40-75%,國內統計近五年類鼻疽致死率則為4.5%。其中糖尿病、肺病、肝病、腎病、癌症或免疫功能受損者等高風險族群,重症機率較高,如有發燒、胸痛、咳嗽等症狀請儘速就醫,即早診斷與治療。疾管署強調,颱風過後為類鼻疽疫情高峰,民眾應做好個人防護措施,避免皮膚、傷口直接接觸或吸入受汙染塵土、土壤及汙水,降低感染機會。如出現疑似症狀時,尤其高風險族群,應儘速就醫並告知汙水、汙泥相關暴露史,以獲得妥善治療;醫師診療遇有疑似個案,應於72小時內通報及採檢送驗,以利衛生單位採取防治措施。

颱風後「類鼻疽」升溫!單週增11例都在南部 疾管署再發醫界通函
疾病管制署(下稱疾管署)今(6日)表示,凱米颱風襲臺帶來強風豪雨,颱風過後國內已確診11例本土類鼻疽病例,均發生於南部縣市,分別為高雄市8例、臺南市2例及嘉義縣1例,年齡介於30多歲至80多歲,其中10位有慢性病史,另1例有酗酒史。目前個案皆住院中,其中3例仍在加護病房治療。因類鼻疽疫情常伴隨颱風侵襲後發生,疾管署今日再度發布致醫界通函,籲請醫師提高警覺,注意類鼻疽疑似個案之通報與診治。依據疾管署監測資料顯示,今年國內已累計18例本土類鼻疽確定病例,為5年以來同期最高,個案發病年齡以65歲以上年齡層為主,居住地分布為高雄市13例、台南市2例、桃園市、彰化縣及嘉義縣各1例。疾管署說明,類鼻疽是由類鼻疽桿菌引起,該菌存在於土壤、水池及積水環境中,主要由皮膚傷口接觸受病原菌污染的土壤或汙水傳染,但也可經由吸入受污染的塵土、土壤或水滴感染;而颱風後疫情常為吸入性感染,於颱風後一個月內確診個案增加。疾管署進一步指出,類鼻疽症狀表現差異極大,可能為無症狀,常見的病徵包括發燒、頭痛、局部腫痛、潰瘍、胸痛、咳嗽、咳血及淋巴結腫大,可導致皮膚膿腫、肺炎、腦炎、敗血症,需儘速以適當抗生素治療。國際上報告類鼻疽死亡率可達40-75%,國內統計近5年類鼻疽致死率則為4.5%。其中糖尿病、肺病、肝病、腎病、癌症或免疫功能受損者等高風險族群,重症機率較高,如有發燒、胸痛、咳嗽等症狀請儘速就醫,即早診斷與治療。疾管署強調,颱風過後為類鼻疽疫情高峰,民眾應做好個人防護措施,避免皮膚、傷口直接接觸或吸入受汙染塵土、土壤及汙水,降低感染機會。如出現疑似症狀時,尤其高風險族群,應儘速就醫並告知汙水、汙泥相關暴露史,以獲得妥善治療;醫師診療遇有疑似個案,應於72小時內通報及採檢送驗,以利衛生單位採取防治措施。

香港鬧區出現多人感染類鼻疽已有6人死亡 港衛生署警告:死亡率可達75%
香港近日發現有29起民眾感染類鼻疽的狀況,甚至已有6人死亡,當中有20起甚至是在鬧區深水埗,港媒更追查類鼻疽菌在區內白田邨、石硤尾邨一帶作惡,水污染可能性相當高,這也讓民眾相當擔心,加上近期入秋又陰雨綿綿,香港衛生署也呼籲民眾要煮沸飲用水,千萬不要直接飲用。香港出現類鼻疽多人感染的狀況,據港媒《東方日報》報導,深水埗區多起奪命的類鼻疽病例,追蹤感染源頭發現類鼻疽菌在白田邨、石硤尾邨一帶猖獗,認為水污染可能性相當高。而香港衛生署也趕緊採樣100個樣本,但當中都沒有發現帶有類鼻疽菌,無法肯定傳染源頭。調查也發現感染個案17名患者,住在16棟不同的大廈中,雖然有多名患者住在同一地區,但沒有飲用未經處理的水,因此排除傳播和食品有關,如今沒有針對類鼻疽研發的疫苗,香港衛生署也建議市民應該避免接觸受汙染的土染與水源,並注意個人衛生。有香港民眾透露因住在山邊,平時有去山上接水飲用的習慣,是否恐會因此感染,衛生署人員則表示仍要將飲用水煮沸才能喝。另外擔心感染源頭是自來水,有關單位也通知水務署,檢查該區供水系統與三個月內維修保養紀錄,但未發現有異常狀況,完全符合香港自來水標準。類鼻疽由感染類鼻疽桿菌(Burkholderia pseudomallei)引起,屬假單孢菌屬革蘭氏陰性桿菌,此菌在土壤、水池及積水環境中存在,會感染馬、羊、豬等動物以及人類,其引致的病名即稱為類鼻疽。其流行地域為東南亞地區及澳洲北部的熱帶地域。
致死率達50%!熱帶細菌潛伏美國本土2年 常引發骨髓炎甚至敗血症
美國疾控和預防中心(CDC)及密西西比州衛生部(MSDH)於27日公布聯合調查報告顯示,他們在墨西哥灣沿岸的土壤樣本中首次發現了一種過去僅存於熱帶氣候環境的致命細菌「類鼻疽伯克氏菌」(Burkholderia pseudomallei),該細菌不但會引發致死率高達50%的類鼻疽病(Melioidosis),更糟糕的是他們可能在2020年就已入侵美國本土。據CBS News、MSDH官網的報導,調查人員最近在密西西比南部的墨西哥灣沿岸土壤中發現了類鼻疽伯克氏菌的蹤跡。MSDH及CDC之所以會啟動這項調查,原因就是該地區在2020年及今年各有1位居民感染了由類鼻疽伯克氏菌引發的類鼻疽病,又被稱為懷特摩爾病(Whitmore's disease)。該菌常在土壤、水池及積水環境中被發現,而且還會透過馬、羊、豬等動物傳染給人類,其臨床表徵類似傷寒或肺結核,感染初期會有發燒、關節痛和頭痛等症狀,常引發肺空洞、膿胸、慢性膿瘍、骨髓炎甚至敗血症等併發症,尤其對糖尿病、慢性腎病、肺病患者以及免疫力低下的患者非常致命,除非病人提早救治並正確使用抗生素,不然致死率高達50%。CDC聲稱,這種細菌過去只存在於波多黎各和美屬維京群島這2個非美國本土的地區,而且醫學界過去普遍認為類鼻疽病是一種只有在熱帶氣候環境才會出現的疾病。然而這次的聯合調查確切證實了,類鼻疽伯克氏菌至少從2020年開始就一直存在於密西西比州,不過當局目前仍不清楚該細菌是否已在當地的土壤和水源中傳開。有關當局現已提醒全國各地的醫師和公衛專家需要特別留意相關病例。另外MSDH的官網也列出了可以避開類鼻疽伯克氏菌感染的做法,包括:避免接觸土壤或泥水,尤其是在下雨過後、用防水藥膏塗抹開放性傷口、從事園藝或農業工作時穿防水靴、戴上手套再接觸土壤等。

罕見「熱帶疾病」首次入侵美國!已4感染2死 CDC:尚未找到關聯
美國近期一連有4人得到一種罕見疾病「類鼻疽」,讓美國疾病控制與預防中心(CDC)不得不在8月9日發出警告,因為這種病以前從未在美國本土被檢測出來過,而之前都是發生在熱帶國家。罹病4人中2人死亡,另2人已經康復。綜合《每日星報》、《新聞週刊》等外媒報導,類鼻疽過去通常出現在南亞、澳洲北部、加勒比海等熱帶地區;過去美國已知的類鼻疽病例發生在加勒比海的維爾京群島和波多黎各,本土從未出現過。(圖/推特)不過,數週之內喬治亞州、堪薩斯州、德州和明尼蘇達州都發現了類鼻疽,罹病的4人在今年3至7月都沒有出國過,首名病例是3月確診、7月底死亡。CDC目前正在緊急調查這波疫情,特別是檢查每一種對抗生素起不了反應的細菌,看看其中有沒有類鼻疽的存在。報導指出,若感染類鼻疽,症狀包括咳嗽、呼吸短促、疲勞、噁心、嘔吐、發燒和皮膚出疹;至於高風險族群則為糖尿病患者、肝腎疾病患者、慢性肺病患者、癌症患者或其他免疫系統較差的人。CDC表示,有可能是因為進口產品中的其中一種成份,才會導致這4人患病,產品可能是食品、飲料、個人護理或清潔產品、藥品等。調查員收集了4名患者家的產品、水、土壤等大量樣本進行檢驗,但目前為止尚未發現4人之間的任何關聯。